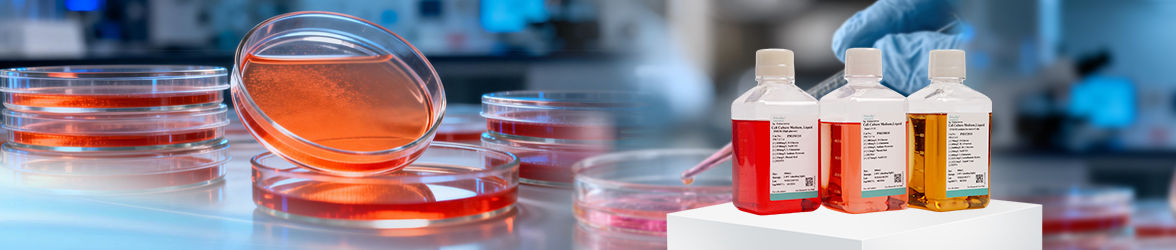
procell-biotechnology

Procell Biotechnology Singapore Pte. Ltd.
La cultura celular profesional impulsa un mundo más saludable
Acerca de Procell Biotechnology
Como líder del mercado en estándares industriales en el sector celular, Procell está especializada en el suministro de productos y servicios de cultivo celular de alta calidad en todo el mundo. Nuestra gama incluye medios de cultivo celular, soluciones tampón y soluciones salinas equilibradas, criomedios, reactivos de disociación celular, suplementos de crecimiento y otros reactivos relacionados con el cultivo celular.
Procell dispone de varias líneas de producción y llenado totalmente automatizadas con capacidad de suministro estable y actualmente alcanza una capacidad de producción diaria de 5.000 litros de medios de base líquida y soluciones tampón. Contamos con un banco de células independiente y nuestros productos han sido verificados con miles de tipos celulares y decenas de millones de validaciones de cultivos celulares para garantizar una calidad superior.
Además, Procell ofrece soluciones personalizadas y aprovecha sus sólidas capacidades de I+D para proporcionar apoyo individualizado a necesidades específicas de investigación e innovación científica.
Cada célula es portadora del secreto y la esperanza de la vida. Nos esforzamos por combinar tecnología punta con servicios bien pensados para proteger su trayectoria investigadora y hacer posible un mundo más sano gracias a la tecnología profesional de cultivo celular.
Folleto corporativo

Encuentre más información sobre Procell Biotechnology Singapore Pte. Ltd. en este folleto corporativo gratuito para descargar.
- Fundación : 2013
- Tema central : Fabricante
- Empleado : 501-1,000
- Sector : Análisis de laboratorio / Tecnología de medición de laboratorio, Biotecnología
- ISO9001
- ISO13485
- ISO45001
- ISO14001
